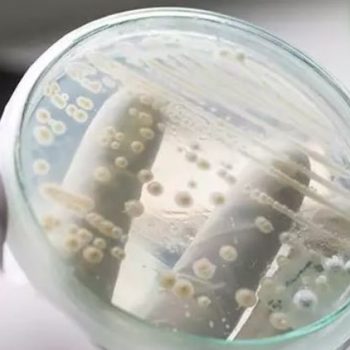

Candida auris: «Βόμβα» Σύψα για πολυανθεκτικό μύκητα στα νοσοκομεία της Αττικής – Τι είπε για την παιδική ηπατίτιδα
«Βόμβα» έπεσε κατά τη διάρκεια συνέντευξης Τύπου που παραχωρούν αυτήν την ώρα σε κεντρικό ξενοδοχείο της Αθήνας τα μέλη της ...
«Βόμβα» έπεσε κατά τη διάρκεια συνέντευξης Τύπου που παραχωρούν αυτήν την ώρα σε κεντρικό ξενοδοχείο της Αθήνας τα μέλη της ...
Ανακοίνωση-απάντηση στα δημοσιεύματα σχετικά με το παθογόνο Candida auris στα νοσοκομεία της χώρας δίνει ο Εθνικός Οργανισμός Δημόσιας Υγείας (ΕΟΔΥ).
Από το 2009 έχει ταυτοποιηθεί ο μύκητας Candida Auris στην Ιαπωνία επισημαίνουν οι επιστήμονες, ο οποίος ενδέχεται να μας απασχολήσει ιδιαίτερα τα επόμενα χρόνια, ...
Περισσότερα από 25 χρόνια υπάρχει ως αίτιο πρόκλησης νοσοκομειακών λοιμώξεων ο μύκητας Candida auris, ο οποίος τους τελευταίους μήνες, λόγω της ...
Επικίνδυνος ο μύκητας Candida auris – Ποια μέτρα προφύλαξης χρειάζονται
Επικίνδυνος ο μύκητας Candida auris – Ποια μέτρα προφύλαξης χρειάζονται12 Μάι 2022
 ΕΟΔΥ: Η ανακοίνωση για τον μύκητα Candida auris – Μέτρα πρόληψης
ΕΟΔΥ: Η ανακοίνωση για τον μύκητα Candida auris – Μέτρα πρόληψης6 Μάι 2022
 Candida Auris: Ο μύκητας που έχει θέσει σε συναγερμό τις ΜΕΘ (VIDEO)
Candida Auris: Ο μύκητας που έχει θέσει σε συναγερμό τις ΜΕΘ (VIDEO)6 Μάι 2022
 Candida auris: «Βόμβα» Σύψα για πολυανθεκτικό μύκητα στα νοσοκομεία της Αττικής – Τι είπε για την παιδική ηπατίτιδα
Candida auris: «Βόμβα» Σύψα για πολυανθεκτικό μύκητα στα νοσοκομεία της Αττικής – Τι είπε για την παιδική ηπατίτιδα5 Μάι 2022
PRODUCED by eTOUCH © VOUCHERERGASIA.GR, 2022 | All rights reserved.
© 2022 voucherergasia.gr - Produced by eTouch.